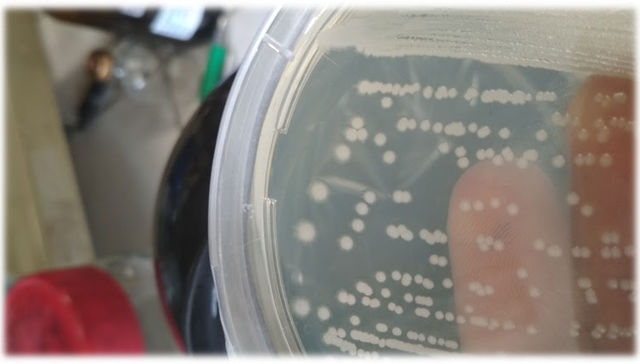
Eureka

Ciencia


Por más ideas disruptivas
Amigos Pasteur: iniciativa del instituto para financiar proyectos guiados por curiosidad

Por The New York Times
Comenzó como un pez, entonces ¿cómo terminó así?

Exageraciones de pescadores
Hallan en los Alpes suizos el mayor diente de dinosaurio marino del mundo

Gracias por el servicio
El telescopio volador Sofia basado en Boeing 747 de la NASA se retira

Tejió su telaraña
Guriurius minuano: la especie de araña número 50.000 habita en Uruguay

Por The New York Times
Prepárate para el nuevo y mejorado segundo

Debate por fuera del laboratorio
Francis Mojica en Uruguay: "Estamos cruzando una barrera que debe ser sometida a debate"

Más de perro
El dingo, más perro que lobo, según nuevo estudio

Escuchar a los que saben
"La historia de CRISPR: un tributo a la curiosidad", charla del científico Francis Mojica

Perseverance y triunfaras
Perseverance llega al delta marciano donde buscará vida pasada

La evolución de las especies
Se cumplen 140 años de la muerte de Charles Darwin, naturalista que en 1833 visitó Uruguay

Está estudiado
Cómo comer una Oreo, según la física de fluidos
Tu tuu tu tu tuuuu tu
Un meteorito que cayó en 2014 no pertenece a nuestro sistema solar